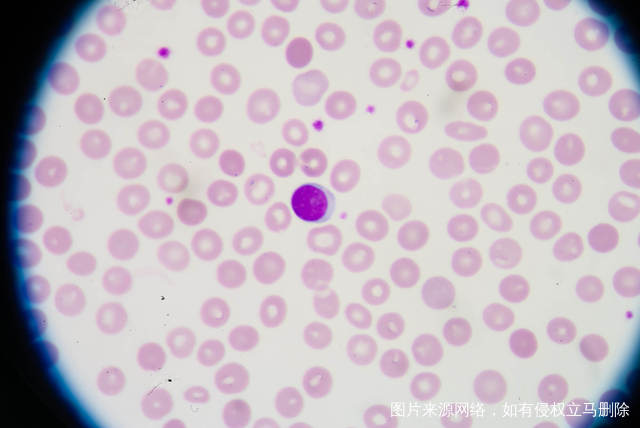

后疫情时代以来,人们的生活习惯和工作习惯正在重新塑造中,虽然很多人依然保持着疫情前的生活节奏,但对新技术和新事物的看法也有了更大的关注和重视。因为生育率的持续走低,我国生育政策的调整十分迅速。再加上科技进步,目前已经有越来越多的家庭选择试管婴儿技术来实现生育梦想。重庆作为我国西部地区的直辖市,试管婴儿技术在近年来取得了显著的发展。本文将为您分享重庆试管婴儿成功率的大数据分析与个性化解读,帮助您更好地了解和选择适合自己的治疗方案。
一、重庆试管婴儿成功率大数据分析
根据大数据统计,重庆试管婴儿的成功率受多种因素影响,包括年龄、技术、医院选择和个体因素。女性年龄在35岁以下时,试管婴儿成功率相对较高;而随着年龄的增长,成功率逐渐降低。此外,技术的进步和医院的专业水平也对成功率有着重要影响。
二、个性化解读
1. 年龄因素:对于高龄女性,选择试管婴儿技术需要更加谨慎。医生会根据患者的具体情况制定个性化的治疗方案,包括药物使用和胚胎筛选策略,以提高成功率。
2. 技术因素:重庆的医院在试管婴儿技术方面不断引进和创新,包括第三代PGT技术、AI辅助高效方案等。这些新技术能够提高胚胎的健康和发育,提高试管婴儿的成功率。患者可以根据自身情况选择合适的技术方案。
3. 医院选择:在重庆,有多家提供试管婴儿技术的医院,但质量参差不齐。选择一家专业、口碑良好的医院对于提高试管婴儿成功率至关重要。患者可以通过网络查询、患者评价等途径了解医院的信息,选择合适的医院。
4. 个体因素:除了年龄、技术和医院选择外,个体因素也会影响试管婴儿的成功率。包括患者的身体健康状况、生活习惯、心理状态等。保持良好的生活习惯,如戒烟、限酒、均衡饮食和适量运动,可以提高成功率。同时,心理状态的调整和支持也是至关重要的。
三、提高试管婴儿成功率的建议
1. 尽早进行试管婴儿治疗:适龄生育是提高成功率的关键,建议尽早进行试管婴儿治疗。
2. 选择专业医院:选择一家专业、口碑良好的医院,能够提供全面、个性化的治疗方案。
3. 注意身体健康:保持良好的生活习惯,提高身体健康状况。
4. 心理支持:试管婴儿过程中心理压力较大,寻求心理支持和辅导。
总之,重庆试管婴儿成功率受到年龄、技术、医院选择和个体因素的影响。了解这些影响因素,选择合适的医院和治疗方案,注意身体健康和心理支持,有助于提高试管婴儿的成功率。祝您早日实现生育梦想!













